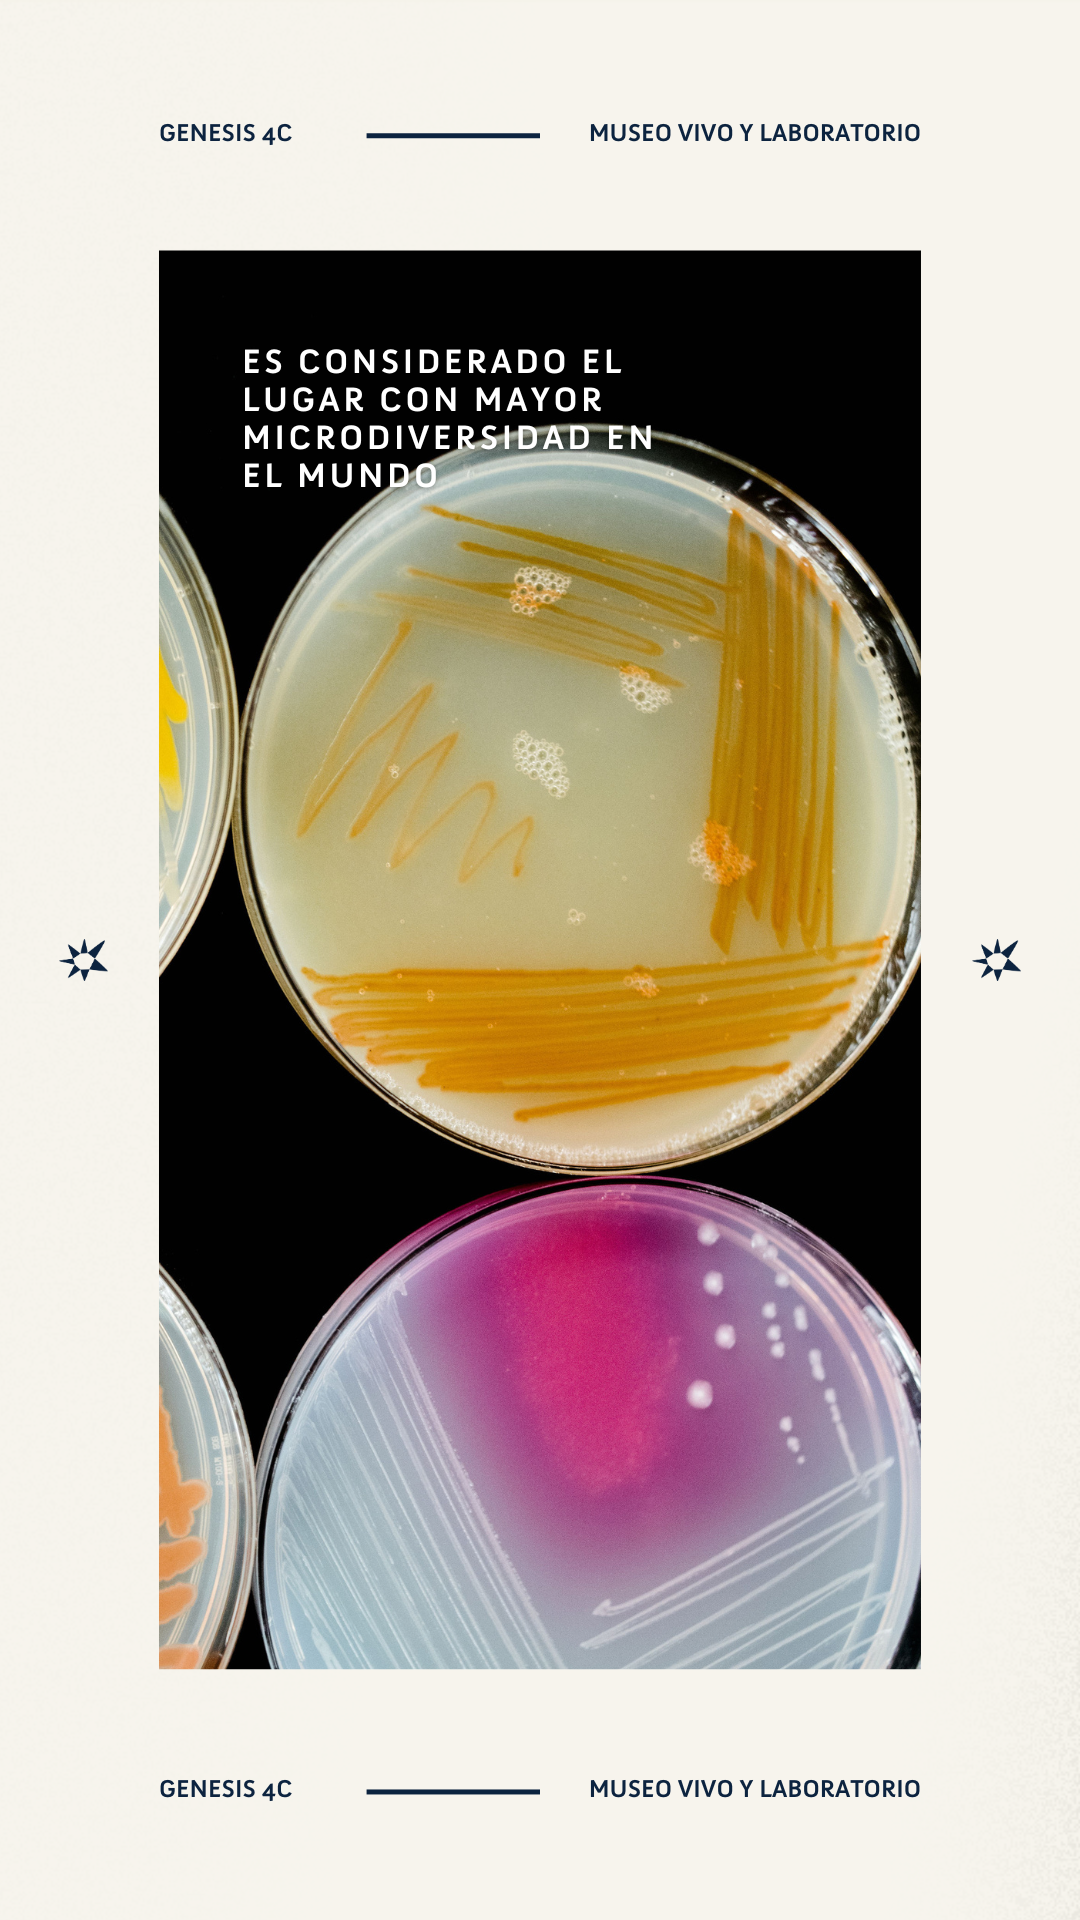

GENESIS
GRUPO ECCO
2022-2024
the brand
Genesis is a brand born to explore and communicate the extraordinary micro-diversity of Cuatro Ciénegas, a small town in the middle of the desert that holds the title of the most micro-diverse place on Earth. Unique microorganisms and bacteria, found nowhere else, thrive in this environment. To harness this scientific treasure, Genesis operates an on-site lab dedicated to researching these microorganisms and developing products based on their properties. Additionally, Genesis features an immersive and interactive museum designed to engage the local community in science, believing that knowledge and appreciation form the foundation for conservation.
the STRATEGY
The social media strategy for Genesis focused on building a cohesive and visually captivating brand presence that reflected the brand’s dedication to science, education, and conservation. Key elements of the strategy included:
Distinctive Visual Language: Establishing a unique and consistent visual identity that captures the scientific innovation and natural beauty of Cuatro Ciénegas, while promoting the brand's commitment to research and preservation.
Content Calendar: Developing a content calendar aligned with current research, museum events, and community projects to maintain a steady stream of engaging content.
Paid Ads: Creating and fine-tuning targeted paid ads designed to reach both science enthusiasts and conservation-minded audiences, with specific funnels tailored to drive awareness of the museum and ongoing research.
Optimized Highlights: Structuring Instagram highlights to provide easy access to key information, including ongoing research, upcoming museum events, and conservation initiatives.
Organic Content: Posting a variety of organic content—such as reels, carousels, posts, and stories—at least three times a week. This content focused on Cuatro Ciénegas' biodiversity, sustainability tips, current research projects, and the importance of conservation efforts.
stories
/
stories /

VIDEOS
/
VIDEOS /
highlights
-

Community
-

Research
-

Museum
-

Explore
-

Lab
-

our book













